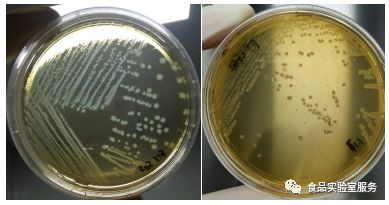
GB 8538中产气荚膜梭菌标准菌株复苏、活化、鉴定
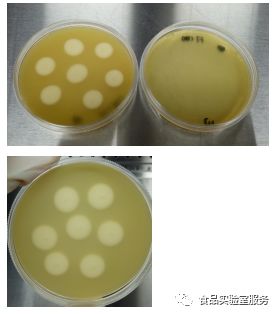
GB 8538中产气荚膜梭菌标准菌株复苏、活化、鉴定

广东环凯生物科技有限公司品牌商
5 年
手机商铺
- NaN
- 0.20000000000000018
- 1.2000000000000002
- 0.20000000000000018
- 3.2
推荐产品
公司新闻/正文
GB 8538中产气荚膜梭菌标准菌株复苏、活化、鉴定
582 人阅读发布时间:2023-11-15 10:21
一:实验准备
1、购买的标准菌株及其使用说明书
2、按照说明书准备所需要的实验耗材
3、大致梳理实验流程,方便实验思路清晰,记录实验中实验现象。
二:菌株活化
按照说明书活化菌株,如下图:

打开安培瓶,用无菌吸管将脑心浸液培养基加入冻干菌种中,混合均匀,将菌悬液吸出接种于哥伦比亚血平板中,于36℃厌氧培养72h。
备注:本实验室购买FSCC137003(ATCC13124)
三:实验操作

1、将哥伦比亚血平板中的菌株接种于SPS平板中,标准上说明产期荚膜梭菌在SPS平板上需要36℃厌氧培养24h,菌落形态为黑色。事实上厌氧效果不达标,SPS平板上菌落形态难以呈黑色。如下图:
备注:
为了呈现黑色菌落,PO主查阅了相关文献:
可以在SPS平板上覆盖一层,以达到厌氧环境,使菌落更呈深灰色。po主所在实验室用日本产的厌氧产气盒和厌氧产气袋以达到更好厌氧效果。为了呈现黑色菌落,特意将一个厌氧袋增加到两个,以达到厌氧环境。
SPS平板中呈现黑色菌落,其形成原理是:SPS即亚硫酸盐-多粘菌素B-磺胺嘧啶琼脂,产气荚膜梭菌可以还原亚硫酸盐为硫醚,硫醚可以与柠檬酸铁铵反应呈黑色。查询文献所知,增加亚硫酸盐的量和柠檬酸铁铵的量,可以增强黑色。
2、将SPS平板中中的菌落分别接种于FT培养基中,于36℃培养24h。
观察形态:有絮状物产生、菌液混浊,产生大量气泡。如下图:

备注:
配制FT培养基时应注意灭菌后迅速冷却,以达到厌氧效果。
标准没有说明36℃培养需要厌氧,楼主这里做了对比,实验证明厌氧培养与未厌氧对实验影响较小。
四:生化反应:
1、镜检
产期荚膜梭菌为革兰氏阳性粗大杆菌,观察镜检形态。如下图:

2、动力-硝酸盐实验
用接种针穿刺动力-硝酸盐培养基,于36℃厌氧培养24h。产气荚膜梭菌无动力,能将硝酸盐还原为亚硝酸盐。如下图:

3、牛奶发酵实验
取FT培养液1ml接种于含铁牛奶培养基中,于46℃水浴培养2h,产气荚膜梭菌能发酵乳糖、凝固酪蛋白并大量产气,呈“暴烈发酵”现象,但培养基不变黑。如下图:

4、卵磷脂分解实验
用接种针取FT培养液点种于卵黄琼脂平板,于36℃厌氧培养24h。产气荚膜梭菌会产生卵磷脂酶,分解卵黄中的卵磷脂,接种点底部及周围形成乳白色的浑浊带。如下图:
五:参考为献
1. GB8538-2016 食品安全国家标准 饮用天然矿泉水检验方法
2. 刘沛 何艳玲主编.北京陆桥技术有限责任公司.《食品安全导刊》2013年第3期
3. 姚积源主编.上海市疾病预防控制中心培养室.上海201204
文章来源:“食品实验室服务”公众号,作者~。
免责声明:转载文章旨在知识分享,如涉及作品内容、版权和其它问题,请联系我们删除!







